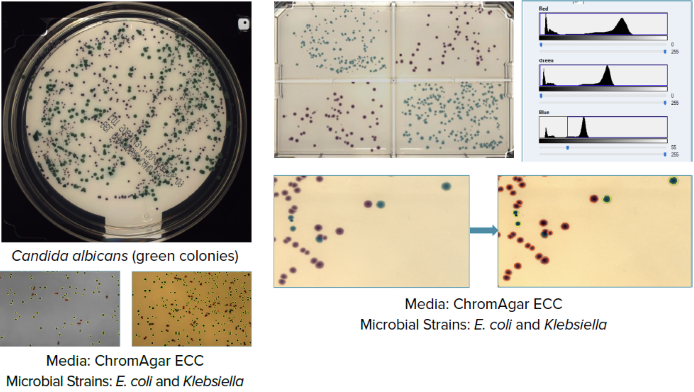

This article is based on a poster originally authored by Krishna Macha, Sushmita Sudarshan, Carina Gao, Oksana Sirenko, and Sheela Muley.
Bacterial and yeast strains are central to microbiology, driving innovations in biotechnology, healthcare, and environmental science, including biofuels, biodegradable materials, and therapeutic protein production.
This article explores an approach to automating workflows and enhancing accuracy and efficiency using the QPix® FLEX™ Microbial Colony Picker, specifically for E. coli and yeast.
Automating colony picking improves workflow, ensures contamination-free environments, and provides reliable data for applications like protein production, gene expression studies, and metabolic analysis.
The study presented here saw E. coli and yeast cultures prepared in overnight growth media before being adjusted to varying concentrations for automated processing.
UV-sterilized instruments and wash troughs were used to maintain sterility, with cultures plated on agar via an automated approach designed to ensure single E. coli colony isolation after 16 hours of incubation and single colony yeast isolation after 16–24 hours.
Colony selection and screening were done based on blue/white screening and colony morphology, such as size and shape. This approach allowed for the precise identification of desired clones, with selected colonies ranging from 0.5 mm to 2 mm for E. coli and 1 mm to 3 mm for yeast.
Colonies were transferred into 96-well culture media plates post-picking in order to allow for further growth. It was observed that the picking process achieved an accuracy of 99%, an efficiency of 95%, and a contamination rate of 0%.
Optical density (OD600) readings were taken to confirm successful cultivation, enabling downstream processes. Colonies were also consolidated through cherry-picking in order to prepare samples for downstream studies.
Integrated data tracking improved the reproducibility of microbial workflows further by mitigating bottlenecks commonly associated with manual methods, for example, picking errors, data tracking, a lack of reproducibility, and long hours.
The workflow described represents a reliable foundation for microbial workflows and sample preparation for future downstream applications, including functional studies and metabolic analysis.
QPix® FLEX™ features and advantages
Bacterial transformation in a microbial lab requires the introduction of DNA into host cells, followed by plating on selective media. Media preparation requires sterility and accuracy, while streaking ensures colony isolation.
Colonies are picked based on specific traits such as color, with hit picking used to identify positive clones for sequencing. Glycerol stocks are also prepared for long-term storage.
There are a number of challenges associated with these workflows, including manual error, risks of contamination, and low throughput. The QPix® FLEX™ system automates plating, streaking, media preparation, colony and color picking, hit selection, sequencing preparation, and glycerol stock creation.
This instrument has been designed to ensure precision and efficiency, streamlining microbial workflows and supporting scientists in the development and execution of trackable, reproducible, and reliable experiments. Its key benefits include:
- Flexibility, with the ability to seamlessly switch between sterilizable and disposable tips, a variety of labware available, and deck layout adaptability.
- Accuracy, thanks to a multipoint ultrasonic sensor and high-precision mechanical stepper.
- Compact design, able to easily fit on a lab bench, in constrained lab spaces, and in anaerobic chambers.
- Sterility, including a UV light, ultrasonic, three-bath washing system with optional HEPA capabilities.
- Traceability, including 2D barcode reading.
- Integrability, thanks to robust automation features.
- Multi-functionality, with the capacity to accommodate liquid handling, plating and streaking, hit picking, and colony picking (color and morphology).

Image Credit: Molecular Devices UK Ltd
Workflow processes
In a microbial lab, bacterial transformation typically involves introducing DNA into host cells, then plating them on selective media. Streaking helps isolate individual colonies, while media preparation demands precision and sterility. Colonies are selected based on traits such as color, and hit picking is used to identify positive clones for sequencing. Glycerol stocks are then created for long-term storage.
These workflows can be prone to challenges like contamination, manual error, and limited throughput. The QPix FLEX system addresses these issues by automating key steps: plating, streaking, media preparation, colony and color picking, hit selection, sequencing prep, and glycerol stock creation. Built for accuracy and efficiency, it helps streamline microbial workflows—making experiments more reproducible, traceable, and reliable.

Figure 1. The microbial workflow involves multiple steps. Image Credit: Molecular Devices UK Ltd
Media handling and inoculation
The QPix® FLEX™ system supports a diverse range of labware and SBS format plates, including 384-, 96-, 48-, 24-, and 6-well plates, and single and 12-well reservoirs and microwell plates.
The system is also able to accommodate 1 mL, 200 µL, and 50 µL tips for flexible media preparation and liquid handling, making it ideally suited to working with bacterial and yeast workflows.
Key liquid handling settings such as dispense and aspiration speeds can be finely tuned to ensure the accurate fluid transfers required for precise and reproducible experiments. This approach often achieves a coefficient of variation (CV) of less than 5%, considerably lower than common manual handling methods.

Figure 2. Deck placements for media or liquid culture preparation with the compatible individual plate maps. Image Credit: Molecular Devices UK Ltd
Plating
![Source plate with user-defined bacteria and dilutions 96-well format (exportable and importable). Figure 4 [Right]. Destination plate with user defined select bacteria and dilutions – 8-well divider plate (exportable and importable)](https://appetitescience.com/images/Article_Images/ImageForArticle_26337_17532721633443421.png)
Figure 3 [Left]. Source plate with user-defined bacteria and dilutions 96-well format (exportable and importable). Figure 4 [Right]. Destination plate with user-defined select bacteria and dilutions – 8-well divider plate (exportable and importable). Image Credit: Molecular Devices UK Ltd

Figure 5. Various concentrations of the bacteria E. coli (blue, white) and Klebsiella (pink) were plated on the agar surfaces. Lowering the volumes with advanced plating or decreasing concentrations yields single colonies to pick from. Image Credit: Molecular Devices UK Ltd
Streaking
The plating/streaking tip is dipped in overnight culture before being used to streak on an Omni-plate (left) and a 9 cm petri dish (right).

Image Credit: Molecular Devices UK Ltd
The image above (left) shows DH5α E. coli expressing β-galactosidase. This has been streaked on LB agar containing 100 μg/mL ampicillin. This example highlights the instrument’s capacity to dip and streak without bacterial concentration dilutions.
Colony picking
Color colony picking was performed using RGB gradient analysis and morphological grouping in order to identify and select microbial colonies.
Candida (green) was isolated from CHROMagar™ Candida, and Klebsiella (purple) and E. coli (blue) were differentiated on CHROMagar™ ECC. The grouping of recombinant E. coli was achieved via blue-white screening on LB agar with ampicillin.
Colonies were picked based on morphology, color, and region (for example, 4- or 8-well divisions), before being transferred into pre-prepared liquid media in a range of well plate formats.
Each colony was assigned a specific well ID to ensure full traceability, with high-resolution plate images captured to allow retrospective analysis. Flexible source-destination mapping was possible during the picking cycle, and it was found that picking efficiency exceeded 95%, with 100% accuracy and no cross-contamination noted during testing.
Image Credit: Molecular Devices UK Ltd
Hit picking
Hit picking is a targeted selection process employed in microbial screening to isolate specific wells for further analysis. Picked wells typically exhibit a desired phenotype or activity, such as bacterial inhibition or growth.
The QPix® FLEX™ system allows researchers to generate a custom hit picking list as a CSV file, defining specific source plate IDs, well positions, and corresponding destination wells.
The CSV file is imported into automated software designed to guide robotic liquid handlers as they accurately transfer selected bacterial colonies (for example, E. coli) from source plates to predefined positions in destination plates.
Leveraging an automated, data-driven approach to hit picking facilitates the efficient consolidation of target strains, minimizing the risk of manual error and streamlining downstream processes such as sequencing, plasmid preparation, or phenotype validation.
The image on the right shows selected colonies picked from the source into the mapped destination plate. This was done based on a curated list in order to enable focused follow-up analysis.

Figure 6. Deck layout. Image Credit: Molecular Devices UK Ltd

Figure 7. Source wells in the hit pick list. Image Credit: Molecular Devices UK Ltd

Figure 8. Destination wells in the hit pick list. Image Credit: Molecular Devices UK Ltd

Figure 9. The destination plate hit picked wells – E. coli in LB broth. Image Credit: Molecular Devices UK Ltd
Downstream processes
Glycerol stocks are essential for long-term preservation of microbial strains, helping maintain genetic stability and support reproducibility across a wide range of downstream applications. However, preparing these stocks manually can be time-consuming and labor-intensive, requiring strict sterility and precise pipetting.
The QPix® FLEX™ system simplifies glycerol stock preparation by supporting 24-tube racks and automating both glycerol addition and aliquoting. It also offers functionality for PCR plate preparation to support downstream sequencing. Post-picking and culturing steps—such as microbial sample collection, preservation, and DNA extraction—are critical for reliable genomic and metabolic profiling.
Well-designed downstream workflows help reduce variability, improve data quality, and speed up synthetic biology and strain validation efforts. By automating these processes, labs can minimize manual errors, increase throughput, and maintain more consistent, reliable strain management pipelines.

Glycerol 50% with source samples after transfer to be frozen (above). Image Credit: Molecular Devices UK Ltd

Three skirted PCR plates prepared using 96-well plate as a source. Image Credit: Molecular Devices UK Ltd
Hypoxic chamber compatible and smaller footprint
Working with microbial cultures in hypoxic (low-oxygen) environments can be especially demanding, requiring precise handling and care. Until now, colony pickers lacked both a compact footprint and the ability to operate effectively within hypoxic chambers.
The QPix® FLEX™ system changes that by offering a compact, efficient solution specifically designed to fit and function in these challenging environments. Its integrated workflow supports seamless operation inside hypoxic chambers, enabling reliable colony picking and microbial analysis—without compromising environmental control. The result is improved throughput and greater ease in managing sensitive cultures.

Figure 10. Hypoxic chamber parameters were optimized, and the QPix FLEX system was used in the growth of bacteria. Image Credit: Molecular Devices UK Ltd

Figure 11. Lactose broth Agar with E. coli in ambient (left), in hypoxic chamber (right). Significant color changes due to pH change were observed in agar with E. coli grown in anerobic conditions. Image Credit: Molecular Devices UK Ltd
Conclusion
The study presented here highlighted the Microbial Colony Picker’s ability to improve accuracy (99%) and efficiency (95%) when processing E. coli and yeast, while also eliminating contamination (0%).
Single colonies—ranging from 0.5–2 mm for E. coli and 1–3 mm for yeast—were successfully isolated using automated plating, UV-sterilized instruments, and blue-white screening. The QPix® FLEX™ system’s integrated tracking features enhanced efficiency, minimized manual errors, and improved reproducibility.
Hit picking and glycerol stock preparation were streamlined through automation, enabling targeted colony selection and long-term microbial preservation while reducing labor-intensive steps. Flexible liquid handling is supported through compatibility with various plate formats and tip volumes, allowing for precise experiments with a coefficient of variation (CV) below 5%—well beyond what’s achievable with manual methods.
RGB gradient analysis enabled accurate species differentiation on selective media such as CHROMagar™ Candida and CHROMagar™ ECC, with 100% accuracy. These capabilities support efficient color-based colony picking and morphological analysis.
The QPix® FLEX™ system also integrates smoothly into hypoxic environments, uniquely supporting low-oxygen chamber workflows while maintaining environmental control and boosting throughput.
Acknowledgments
Produced from materials originally authored by Molecular Devices UK Ltd.
About Molecular Devices UK Ltd
Molecular Devices is one of the world’s leading providers of high-performance bioanalytical measurement systems, software and consumables for life science research, pharmaceutical and biotherapeutic development. Included within a broad product portfolio are platforms for high-throughput screening, genomic and cellular analysis, colony selection and microplate detection. These leading-edge products enable scientists to improve productivity and effectiveness, ultimately accelerating research and the discovery of new therapeutics. Molecular Devices is committed to the continual development of innovative solutions for life science applications. The company is headquartered in Silicon Valley, California, with offices around the globe. For more information, please visit www.moleculardevices.com.
Sponsored Content Policy: News-Medical.net publishes articles and related content that may be derived from sources where we have existing commercial relationships, provided such content adds value to the core editorial ethos of News-Medical.Net which is to educate and inform site visitors interested in medical research, science, medical devices and treatments.
Last Updated: Jul 24, 2025